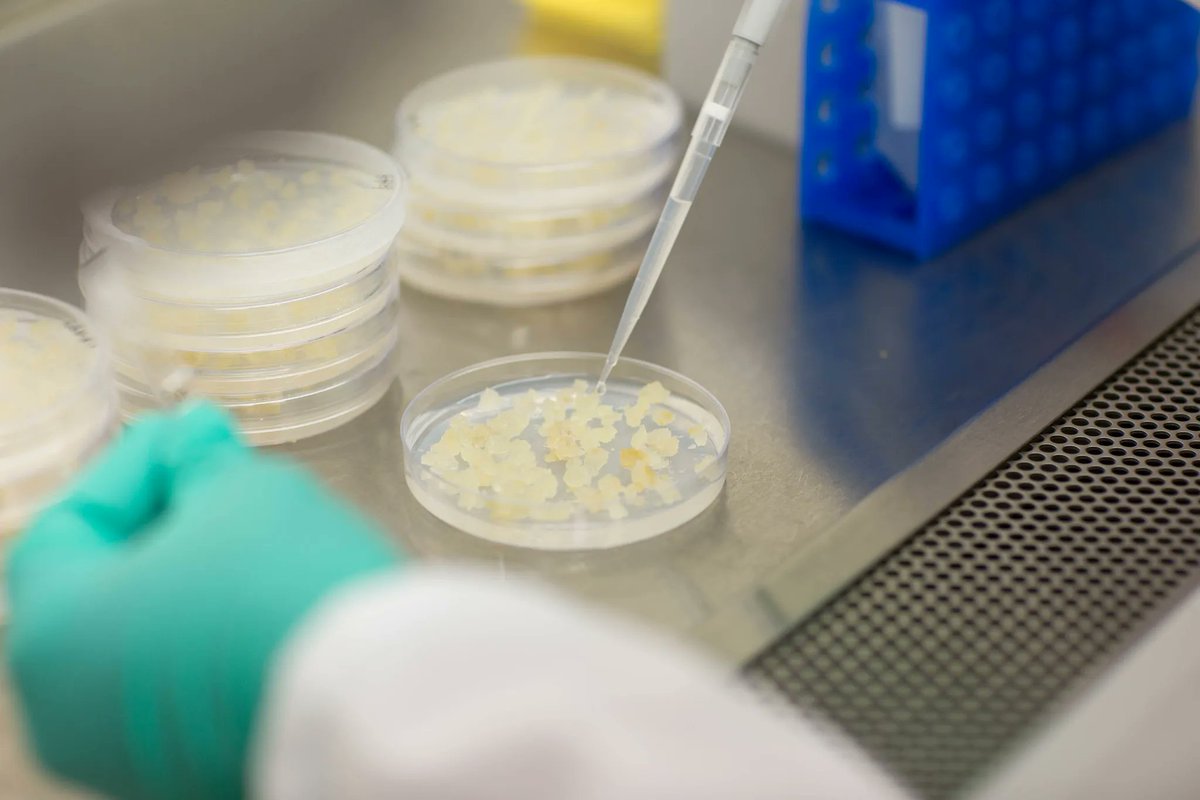
Sul taciuto via libera ai nuovi Ogm. Nel “decreto siccità” è stata infilata una norma che contraddice gli obblighi internazionali dell’Italia in materia di diversità biologica. Ma il silenzio è assordante. La rubrica di <a href="/NDentico/">Nicoletta Dentico</a> 
altreconomia.it/sul-taciuto-vi…

Stefano Prato
@stefprato
Managing Director, Society for International Development (SID)
ID: 347731091
http://www.sidint.net 03-08-2011 08:00:36
1,1K Tweet
1,1K Followers
495 Following

We are proud to host in Relaciones Exteriores 🇲🇽 the 7th Retreat of the Group of #FriendsOfMonterrey to discuss in an open and informal space the most pressing issues on the Financing for Development #FfD process including addressing the 3 Rio Conventions through sustainable financing UN DESA


#Read: Our letter to UN Secretary General António Guterres on supporting and welcoming the UNGA Resolution 77/244 on promotion of inclusive and effective international tax cooperation at the UN. #TaxJustice Eurodad Global Alliance for Tax Justice (GATJ) Tax Justice Network Bsky: @taxjustice.net Tax Justice Network Africa csoforffd.org/2023/03/21/let…

SID joins 90 civil society organizations and trade unions in reiterating that United Nations remains the only universal body where all countries participate as equals and the consensus adoption of Resolution 77/244 marks a historic turning point in international tax cooperation. #TaxJustice


Happening Today! Join us for our side event 'The Road to a UN Tax Convention' as we unpack the proposed United Nations led intergovernmental tax process. 📅 17 Apr 🕒 1.30 PM EST 📍UN HQ #TaxJustice #Fin4Dev #FfD4 Global Alliance for Tax Justice (GATJ) Tax Justice Network Africa Tax Justice Network Bsky: @taxjustice.net



Sul taciuto via libera ai nuovi Ogm. Nel “decreto siccità” è stata infilata una norma che contraddice gli obblighi internazionali dell’Italia in materia di diversità biologica. Ma il silenzio è assordante. La rubrica di Nicoletta Dentico altreconomia.it/sul-taciuto-vi…

Penultimate panel discussing linkages between policy processes the real economy; linking movements across regions; during the #AfCoDDIII in #Dakar with Stefano Prato Emilia Reyes Dr. Ibrahima Aidara Anne-Marie Dias Borges Dereje Alemayehu Society for International Development Global Alliance for Tax Justice (GATJ)


"This week will witness either a historic achievement in creating a more equitable global economy or a terrible failure"- Jayati Ghosh Joseph E. Stiglitz & Jose Antonio Ocampo on the #UNTaxConvention project-syndicate.org/commentary/bac…




















